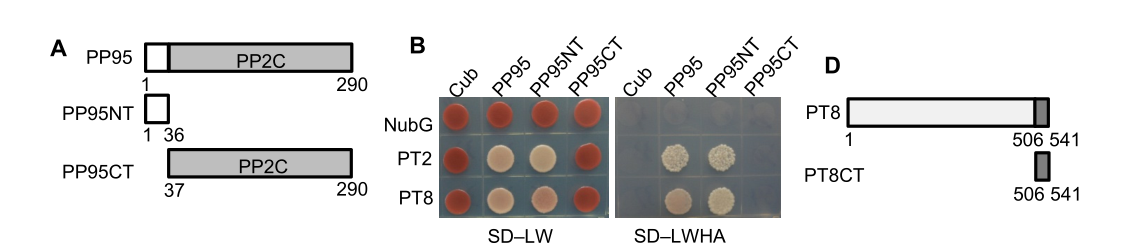

膜系统酵母文库
DUAL membrane 系统(DUAL membrane system)首先由瑞士的Dualsystems Biotech AG 公司开发出来,是基于分离的泛素(split-ubiquitin)介导的膜蛋白酵母双杂交系统,泛素可以分成两部分表达,即其N端部分(NubI)和C端部分(Cub),后者融合有能启动核内报告基因表达的LexA蛋白。NubI和Cub-LexA在细胞中组成可分离的泛素蛋白体系,断裂的泛素的两部分分别连接一个蛋白,且两个蛋白之间存在相互作用。它提供了不同于常规酵母双杂交系统的蛋白体内分析方法,使得分析膜蛋白间的互作成为现实。
其主要特点是可以进行膜蛋白-膜蛋白、膜蛋白-可溶性蛋白间的互作研究。它既可以用于表达文库的筛选,也可以应用于两个已知蛋白(其中一个属于膜蛋白)间互作关系的验证
实验原理
1、泛素(ubiquitin)可以分成两部分:N端(Nub)和C端(Cub);
2、Nub与Cub有很强的亲和力,当在同一细胞同时表达时,Nub与Cub会结合形成完整的泛素,会被泛素蛋白酶(UBPs)识别并切割;
3、Nub第三位的异亮氨酸突变成甘氨酸后(NubI→NubG),Nub与Cub的亲和力大大降低。
4、Cub融合转录因子LexA-VP16,诱饵构建在Cub上,猎物构建在NubG上;
5、当诱饵与猎物互作,使得Cub与NubG靠近而形成完整的泛素,UBPs识别并切割;
6、被切下的转录因子LexA-VP16 进入核内,启动报告基因(His,Ade,LacZ)的表达。

技术优势
1、在体内原位检测蛋白-蛋白间的相互作用而无需核定位信号
2、使用小的泛素结构域(NubG/Cub)使得相互作用蛋白质之间的空间位阻最小化
3、蛋白间的互作信号靠泛素特异性结合蛋白(UBPs)剪切人工转录因子(LexA)启动,而不是靠转录,因此可以检测蛋白自身的转录激活或抑制序列
4、此体系可以用来研究两个膜蛋白的相互作用和一个膜蛋白与一个胞质蛋白的相互作用
5、任何一种膜蛋白都可以作为诱饵,能使与待检测蛋白融合的相互作用模块(Cub-PLV-NubG)定位在细胞质内
诱饵载体的选择方式

膜体系酵母文库构建
实验步骤
1.提取样本总RNA
2.cDNA合成与扩增
3.将cDNA连接到pPR3-N载体上
4.将连接好文库载体电转化大肠杆菌感受态细胞
5.收集文库及文库质量检测
交付情况
1.醇母文库甘油菌1.0ml EP管(4管)
2.酵母文库质粒400ug
3.Word文档电子版项目报告(含实验数据)
膜体系酵母文库筛选
实验步骤
1.将Bait-PBT3载体转化到NMY51宿主细胞
获得Bait-PBT3-NMY51细胞
2.将文库质粒共转化到Bait-PBT3-NMY51细胞
3.摸索试用适当的筛选压力进行文库筛选并测序
交付情况
1.阳性克隆测序结果(根据测序结果而定)
2.阳性克隆酵母序列≥20个
3.Word文档电子版顶目报告(含实验数据)
图片展示
如何判断是膜体系还是核体系?
如何判断是膜体系还是核体系?
酵母双杂实验过程中如何选择核体系或者膜体系?
主要是根据所关注的诱饵蛋白在细胞内的定位情况来确定:
1) 诱饵基因是定位在膜上的蛋白,则选择膜体系文库;
2) 诱饵基因是定位于核,则选择核体系文库;
3) 诱饵基因是定位在细胞质,可以选择核体系或者膜体系文库;